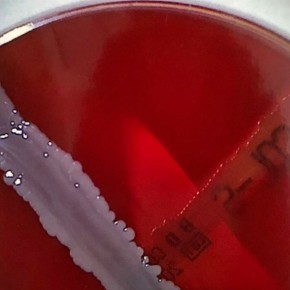
Columbia Sheep Blood Agar ready - 20 pcs.

You might also be interested in the following products
EUR 16,00 - EUR 23,00
add. 19 % VAT excl. shipping costs
Micronaut plates for urology for Germany, only
The MICRONAUT-UR 96-well plates are designed for identification (54 taxa) and...
EUR 664,00
add. 19 % VAT excl. shipping costs
MacConkey/Columbia-CNA biplate agar - 20 pcs.
MacConkey II Agar is a selective differentiation medium for the isolation and...
EUR 14,20 - EUR 15,00
add. 19 % VAT excl. shipping costs
Columbia Sheep Blood CNA Agar II - 20 pcs.Columbia Sheep Blood CNA Agar II - 20 pcs.Columbia Sheep B
EUR 8,95 - EUR 9,15
add. 19 % VAT excl. shipping costs
MacConkey agar ready - 20 pcs.
The MacConkey medium is a selective medium for the preferential cultivation of...
EUR 8,50 - EUR 8,95
add. 19 % VAT excl. shipping costs
U11 Plus urine test strips (150) comp. with DocUReader 2 PRO
LabStrip U11 Plus is a high-grade, non-bleeding multiparameter urinalysis test...
EUR 16,50 - EUR 19,95
add. 19 % VAT excl. shipping costs
10 µl inocculation loops (1000p.) (50 x 20p; sterilized)
Disposable inoculation loops for inoculating culture media (loop) and for picking...
EUR 36,40 - EUR 41,10
add. 19 % VAT excl. shipping costs
Last viewed
Customers also purchased
Kontakt
Bei Rückfragen erreichen Sie unser Kundenbüro telefonisch unter +49 201 21961-701 werktags von 8:00-12:00 und 13:00-17:00 Uhr.
Alternativ schicken Sie uns ein Fax an +49 2573 69795-9917 oder eine E-Mail an service@aurosan.de
Vielen Dank, Ihr Team von AUROSAN.
AUROSAN GmbH | Frankenstr. 231, D-45134 Essen | Tel. +49 201 21961-701 | Fax +49 2573 69795-9917
service@aurosan.de | www.aurosan.de | www.aurosan-shop.de | www.aurosan-gesundes-leben.de